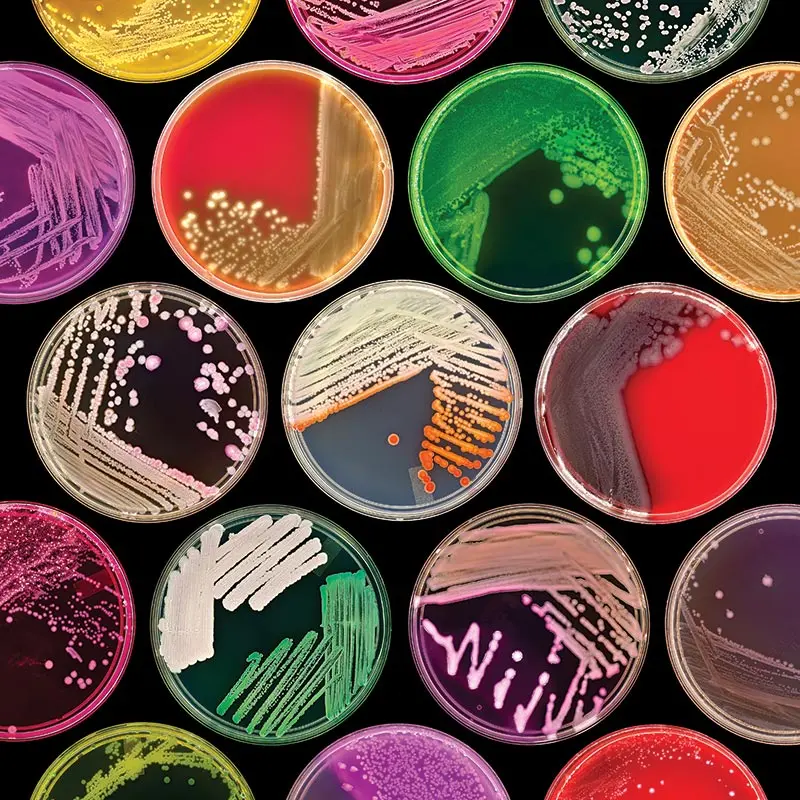

YÜKSƏK KEYFİYYƏT
Unolab MMC öz müştərilərinə yüksək keyfiyyətli, dünya və avropa standartlarının tələblərinə cavab verən, müxtəlif laboratoriya cihazlarını, reagentlərini, sərfiyyatlarını və s. təklif edir.

İŞ SAATLARI
Bazar ertəsi-Cümə
Şənbə
Bazar
08:30 - 17:30
09:00 - 13:00
Bağlıdır

SERVİS XİDMƏTLƏRİ
Unolab MMC öz müştərilərinə cihazların quraşdırılması, quraşdırılmış cihazlara reagentlərin tanıdılması, ilkin məsləhət və təlimatlandırma və s kimi xidmətlər təklif edir.
MƏHSULLAR

Tam Avtomat Klinik Kimyəvi Analizator (Mispa CXL Pro Plus)-Agappe
Avtomat cihazlar

XL1000C - Avtomat Koaqulyasiya Analizatoru-Zonci
Avtomat cihazlar

CoagL - Avtomat Koaqulometr 160 PT test / saat
Avtomat cihazlar

DM0408 Centrifuge-DLAB
Sentrifuqalar

SK-D3309-Pro LCD Digital 3D Shaker-DLAB
Şeykerlər

Coag2D – 2-channel manual coagulometer
Digər cihazlar
XƏBƏRLƏR

PT (Protrombin vaxtı) testi
Bu testlərə PT (protrombin vaxtı), APTT (hissəvi tromboplastin vaxtı), Fİbrinogen və TT (trombin vaxtı) daxildir.
• PT testi xarici faktorların (məsələn: VII Faktor) və ümuni faktorların (məslən: Faktor X, V, II, fibrinogen) çatışmazlığını və inhibitorlarını qiymətləndirmək üçün aparılır.
• PT ölçülməsi
PT reagenti toxuma faktoru (həmçinin tromboplastin kimi tanınır), fosfolipidlər və kalsium xlorid mənbəyinidir. Plazma 37 °C-ə qədər qızdırılır, əvvəlcədən isidilmiş PT reagenti əlavə edilir və laxtanın əmələ gəlməsi üçün vaxt saniyələrlə ölçülür. PT dəyərləri istifadə olunan reagent və cihazdan asılıdır və normativi laboratoriyalar özləri təyin edir. Normal PT təxminən 9-15 saniyədir.
Beynəlxalq Normallaşdırılmış Nisbət (INR)
• Beynəlxalq Normallaşdırılmış Nisbət (INR) müxtəlif laboratoriyalarda oral vitamin K antoqonist terapiyasının (məsələn, warfarin) monitorinqinə imkan vermək üçün PT-ni standartlaşdırmaq üçün hazırlanmışdır. INR-ni hesablamaq üçün saniyələrlə PT vaxtı istifadə olunur.
• PT reagentinin hər bir partiyasının Beynəlxalq Həssaslıq İndeksi (ISI) müəyyən edilmiş/təyin edilmiş olmalıdır ki, bu da reagentin Ümumdünya Səhiyyə Təşkilatının istinad standartı ilə müqayisədə Vitamin K-dan asılı amillərdəki çatışmazlıqlara nə dərəcədə həssas olduğunu göstərir.
• INR-in hesablanması üçün xəstənin PT dəyərinin (san), PT-nin normal dəyərinin həndəsi ortasına bölüb, (minimum 20 normal könüllüdən alınmış) reagentin ISI dəyərində qüvvətinə yüksəldilir:
INR = (xəstənin PT / orta normal PT)ISI
APTT (aktivləşmiş hissəvi tromboplastin vaxtı) testi
• APTT (aktiv hissəvi tromboplastin vaxtı), daxili faktorların (Faktor XII, XI, IX, VIII) və ümumi faktorların (Faktor X, I, II, Fibrinogen) çatışmazlıqlarını və ya inhibitorlarını qiymətləndirmək üçün istifadə olunur.
• APTT ölçülməsi:
• APTT Reagenti tərkibində kontakt aktivatoru (məsələn, silisium, ellaidin turşusu və ya kaolin) və fosfolipidlər var, ancaq toxuma faktoru və ya kalsium xlorid yoxdur.
• Xəstə plazması APTT reaktivi ilə qarışdırıldıqda və 37 °C-də inkubasiya edildikdə, daxili faktorlar "aktivləşdirilir".
• Kalsium xlorid əlavə olunur və laxtalanma vaxtı ölçülür.
• APTT reagentində toxuma faktoru olmadığı üçün onun adına "hissəvi tromboplastin" testi və ya aktivləşdirilmiş hissəvi tromboplastin vaxtı deyilir.
• APTT dəyəri istifadə olunan reaktiv və ölçü cihazından asılıdır və normativi laboratoriyalar özləri təyin edir. Normal APTT dəyəri təxminən 25-35 saniyə təşkil edir.
TT (trombin vaxtı) testi
• TT fibrinogen çatışmazlığı yaxud disfunksiyası və ya trombinin inhibitorunun (Faktor IIa) mövcudluğunu qiymətləndirmək üçün istifadə olunur. TT müddətinin uzanmasının ən ümumi səbəbi antikoaqulyant dərman müalicəsidir (məsələn, heparin və ya birbaşa trombin inhibitoru). Digər səbəblərə kəmiyyət və ya keyfiyyət baxımından fibrinogen anormallıqları və laxtalanmanın artması məhsulları (məsələn, yayılmış intravaskulyar laxtalanmada fibrin deqradasiyası məhsulları) daxildir.
TT ölçülməsi
• Xəstənin plazması 37°C-də qızdırılır və trombin reagenti əlavə edilir. Plazmanın laxtalanması üçün lazım olan vaxt saniyələrlə ölçülür
• TT nəticələri istifadə olunan reagent və ölçü cihazından asılıdır və normativi laboratoriyalar özləri təyin edir.
Fibrinogen testi
• Fibrinogen analizi fibrinogen aktivliyini qiymətləndirir.
• Hipofibrinogenemiya adətən fibrinogen itkisi (məsələn, qanaxma), istifadə olunma (məsələn, travmatik zədədən sonra hiperfibrinoliz, yayılmış damardaxili laxtalanma) və ya sintezin zəifləməsi (məsələn, ağır qaraciyər xəstəliyi) nəticəsində baş verir. Digər nadir səbəblər isə anadangəlmə hipofibrinogenemiya və disfibrinogenemiya (anormal fibrinogen) aiddir.
• Fibrinogen kəskin faza reaktividir və kəskin və ya xroniki iltihab zamanı qeyri-spesifik olaraq yüksələ bilər.
Klauss metodu əsasında fibrinogenin ölçülməsi:
• Plazma fizioloji məhlul ilə durulaşdırılır, 37 ° C-ə qədər qızdırılır və yüksək konsentrasiyada trombin əlavə edilir. Trombin fibrinogeni polimerləşən fibrin monomerlərinə ayırır. Plazmanın laxtalanma müddəti saniyələrlə ölçülür. Saniyədə vaxt standart kalibrasiya əyrisindən əldə edilən fibrinogen aktivliyi ilə tərs mütənasibdir. Laxtalanma müddəti nə qədər uzun olarsa, nümunədə fibrinogenin konsentrasiyası bir o qədər aşağı olar.
• Laboratoriyalar kalibrasiya əyrisi üçün ÜST tərəfindən kalibrlənmiş plazmadan istifadə etdiyinə görə Klauss fibrinogen aktivliyi standartlaşdırılmış testdir. Laboratoriyalar arasında referans aralıqlarında kiçik fərqlər olması mümkün olsa da, referans aralığı təxminən 1,5-4 q/l təşkil edir.
D-dimer testi
• D-dimerlər, plazminin çarpaz birləşmiş fibrinə təsiri nəticəsində yaranan parçalanma məhsullarıdır. D-dimer iki çarpaz birləşmiş D fraqmentindən ibarətdir.
• Mənfi D-dimer bəzi ambulator xəstələrdə (VTE-nin aşağı və ya orta dərəcədə klinik ehtimalı olan) venoz tromboemboliyanı (VTE) istisna etmək üçün istifadə edilə bilər. D-dimer yalnız təsdiqlənmiş VTE diaqnostik alqoritminin bir hissəsi kimi istifadə edilməlidir.
• Yüksək D-dimer tromboza xas deyil və bir sıra digər qeyri-spesifik xəstəliklər və ya iltihablı vəziyyətlərlə (məsələn, cərrahiyyə və ya travma, xərçəng, kəskin və ya xroniki yoluxucu və ya iltihablı xəstəliklər, yayılmış damardaxili laxtalanma, normal hamiləlik və s.) ilə əlaqəli ola bilər.
D-dimerin ölçülməsi:
• D-dimerin ölçülməsi üçün bir neçə fərqli analiz mövcuddur. Bunlara D-dimerin müxtəlif epitoplarına monoklonal antitellərdən istifadə edən ELISA (Fermentlə Bağlı İmmunosorbent Test) və ya LIA (Lateks İmmuntest) kimi keyfiyyət (müsbət və ya mənfi), yarı kəmiyyət və ya kəmiyyət üsulları daxildir. Müxtəlif analizlərlə əldə edilən D-dimer kəmiyyət nəticələri istifadə edilən monoklonal antitelin dəyişkənliyinə görə qeyri-standartdır. Ona görə də D-dimer nəticələri istifadə olunan analiz əsasında şərh edilməlidir. Vahidlər analizlər arasında dəyişir, məs. DDU (D-dimer vahidləri) və ya FEU (Fibrinogen ekvivalent vahidləri).
Bu testlərə PT (protrombin vaxtı), APTT (hissəvi tromboplastin vaxtı), Fİbrinogen və TT (trombin vaxtı) daxildir.
• PT testi xarici faktorların (məsələn: VII Faktor) və ümuni faktorların (məslən: Faktor X, V, II, fibrinogen) çatışmazlığını və inhibitorlarını qiymətləndirmək üçün aparılır.
• PT ölçülməsi
PT reagenti toxuma faktoru (həmçinin tromboplastin kimi tanınır), fosfolipidlər və kalsium xlorid mənbəyinidir. Plazma 37 °C-ə qədər qızdırılır, əvvəlcədən isidilmiş PT reagenti əlavə edilir və laxtanın əmələ gəlməsi üçün vaxt saniyələrlə ölçülür. PT dəyərləri istifadə olunan reagent və cihazdan asılıdır və normativi laboratoriyalar özləri təyin edir. Normal PT təxminən 9-15 saniyədir.
Beynəlxalq Normallaşdırılmış Nisbət (INR)
• Beynəlxalq Normallaşdırılmış Nisbət (INR) müxtəlif laboratoriyalarda oral vitamin K antoqonist terapiyasının (məsələn, warfarin) monitorinqinə imkan vermək üçün PT-ni standartlaşdırmaq üçün hazırlanmışdır. INR-ni hesablamaq üçün saniyələrlə PT vaxtı istifadə olunur.
• PT reagentinin hər bir partiyasının Beynəlxalq Həssaslıq İndeksi (ISI) müəyyən edilmiş/təyin edilmiş olmalıdır ki, bu da reagentin Ümumdünya Səhiyyə Təşkilatının istinad standartı ilə müqayisədə Vitamin K-dan asılı amillərdəki çatışmazlıqlara nə dərəcədə həssas olduğunu göstərir.
• INR-in hesablanması üçün xəstənin PT dəyərinin (san), PT-nin normal dəyərinin həndəsi ortasına bölüb, (minimum 20 normal könüllüdən alınmış) reagentin ISI dəyərində qüvvətinə yüksəldilir:
INR = (xəstənin PT / orta normal PT)ISI
APTT (aktivləşmiş hissəvi tromboplastin vaxtı) testi
• APTT (aktiv hissəvi tromboplastin vaxtı), daxili faktorların (Faktor XII, XI, IX, VIII) və ümumi faktorların (Faktor X, I, II, Fibrinogen) çatışmazlıqlarını və ya inhibitorlarını qiymətləndirmək üçün istifadə olunur.
• APTT ölçülməsi:
• APTT Reagenti tərkibində kontakt aktivatoru (məsələn, silisium, ellaidin turşusu və ya kaolin) və fosfolipidlər var, ancaq toxuma faktoru və ya kalsium xlorid yoxdur.
• Xəstə plazması APTT reaktivi ilə qarışdırıldıqda və 37 °C-də inkubasiya edildikdə, daxili faktorlar "aktivləşdirilir".
• Kalsium xlorid əlavə olunur və laxtalanma vaxtı ölçülür.
• APTT reagentində toxuma faktoru olmadığı üçün onun adına "hissəvi tromboplastin" testi və ya aktivləşdirilmiş hissəvi tromboplastin vaxtı deyilir.
• APTT dəyəri istifadə olunan reaktiv və ölçü cihazından asılıdır və normativi laboratoriyalar özləri təyin edir. Normal APTT dəyəri təxminən 25-35 saniyə təşkil edir.
TT (trombin vaxtı) testi
• TT fibrinogen çatışmazlığı yaxud disfunksiyası və ya trombinin inhibitorunun (Faktor IIa) mövcudluğunu qiymətləndirmək üçün istifadə olunur. TT müddətinin uzanmasının ən ümumi səbəbi antikoaqulyant dərman müalicəsidir (məsələn, heparin və ya birbaşa trombin inhibitoru). Digər səbəblərə kəmiyyət və ya keyfiyyət baxımından fibrinogen anormallıqları və laxtalanmanın artması məhsulları (məsələn, yayılmış intravaskulyar laxtalanmada fibrin deqradasiyası məhsulları) daxildir.
TT ölçülməsi
• Xəstənin plazması 37°C-də qızdırılır və trombin reagenti əlavə edilir. Plazmanın laxtalanması üçün lazım olan vaxt saniyələrlə ölçülür
• TT nəticələri istifadə olunan reagent və ölçü cihazından asılıdır və normativi laboratoriyalar özləri təyin edir.
Fibrinogen testi
• Fibrinogen analizi fibrinogen aktivliyini qiymətləndirir.
• Hipofibrinogenemiya adətən fibrinogen itkisi (məsələn, qanaxma), istifadə olunma (məsələn, travmatik zədədən sonra hiperfibrinoliz, yayılmış damardaxili laxtalanma) və ya sintezin zəifləməsi (məsələn, ağır qaraciyər xəstəliyi) nəticəsində baş verir. Digər nadir səbəblər isə anadangəlmə hipofibrinogenemiya və disfibrinogenemiya (anormal fibrinogen) aiddir.
• Fibrinogen kəskin faza reaktividir və kəskin və ya xroniki iltihab zamanı qeyri-spesifik olaraq yüksələ bilər.
Klauss metodu əsasında fibrinogenin ölçülməsi:
• Plazma fizioloji məhlul ilə durulaşdırılır, 37 ° C-ə qədər qızdırılır və yüksək konsentrasiyada trombin əlavə edilir. Trombin fibrinogeni polimerləşən fibrin monomerlərinə ayırır. Plazmanın laxtalanma müddəti saniyələrlə ölçülür. Saniyədə vaxt standart kalibrasiya əyrisindən əldə edilən fibrinogen aktivliyi ilə tərs mütənasibdir. Laxtalanma müddəti nə qədər uzun olarsa, nümunədə fibrinogenin konsentrasiyası bir o qədər aşağı olar.
• Laboratoriyalar kalibrasiya əyrisi üçün ÜST tərəfindən kalibrlənmiş plazmadan istifadə etdiyinə görə Klauss fibrinogen aktivliyi standartlaşdırılmış testdir. Laboratoriyalar arasında referans aralıqlarında kiçik fərqlər olması mümkün olsa da, referans aralığı təxminən 1,5-4 q/l təşkil edir.
D-dimer testi
• D-dimerlər, plazminin çarpaz birləşmiş fibrinə təsiri nəticəsində yaranan parçalanma məhsullarıdır. D-dimer iki çarpaz birləşmiş D fraqmentindən ibarətdir.
• Mənfi D-dimer bəzi ambulator xəstələrdə (VTE-nin aşağı və ya orta dərəcədə klinik ehtimalı olan) venoz tromboemboliyanı (VTE) istisna etmək üçün istifadə edilə bilər. D-dimer yalnız təsdiqlənmiş VTE diaqnostik alqoritminin bir hissəsi kimi istifadə edilməlidir.
• Yüksək D-dimer tromboza xas deyil və bir sıra digər qeyri-spesifik xəstəliklər və ya iltihablı vəziyyətlərlə (məsələn, cərrahiyyə və ya travma, xərçəng, kəskin və ya xroniki yoluxucu və ya iltihablı xəstəliklər, yayılmış damardaxili laxtalanma, normal hamiləlik və s.) ilə əlaqəli ola bilər.
D-dimerin ölçülməsi:
• D-dimerin ölçülməsi üçün bir neçə fərqli analiz mövcuddur. Bunlara D-dimerin müxtəlif epitoplarına monoklonal antitellərdən istifadə edən ELISA (Fermentlə Bağlı İmmunosorbent Test) və ya LIA (Lateks İmmuntest) kimi keyfiyyət (müsbət və ya mənfi), yarı kəmiyyət və ya kəmiyyət üsulları daxildir. Müxtəlif analizlərlə əldə edilən D-dimer kəmiyyət nəticələri istifadə edilən monoklonal antitelin dəyişkənliyinə görə qeyri-standartdır. Ona görə də D-dimer nəticələri istifadə olunan analiz əsasında şərh edilməlidir. Vahidlər analizlər arasında dəyişir, məs. DDU (D-dimer vahidləri) və ya FEU (Fibrinogen ekvivalent vahidləri).

Hemostaz qanaxmanı idarə etmək üçün damar zədələnməsinə cavab olaraq qan laxtalanma sisteminin çoxsaylı komponentlərinin aktivləşdirildiyi mürəkkəb bir prosesdir.
Hemostazın 4 əsas hissədən ibarətdir:
1. İlkin hemostaz
2. İkincili hemostaz
3. Fibrin formalaşması və stabilləşməsi
4. Laxtalanma inhibitorları
1. İlkin hemostaz – vazokonstruksiya və trombosit laxtasının əmələ gəlməsi:
İlkin hemostazın əsas komponenti trombositdir. İlkin hemostaz subendotelial kollagen müşahidə olunan damar divarının zədələnməsi ilə baş verir
• Vazokonstruksiya: Qan axışını azaltmaq üçün zədə yerində vazokonstruksiya əmələ gəlir.
Yapışma: von Willebrand faktoru trombosit qlikoprotein Ib (GPIb) reseptoru vasitəsi ilə trombositləri meyudana çıxan subendotelial kollagenə yapışdırır. Digər reseptorlar da trombositlərin birbaşa kollagenə yapışmasına şərait yaradır.
Toplanma: Trombositlər GPIb reseptorlarına birləşmiş fibrinogen hesabına bir zədələnmiş damar nahiyəsində toplanır və beləliklə trombosit tıxacı əmələ gətirir. Trombositlərin toplanması həmçinin laxtalanma faktorlarının aktivləşməsini təmin edən fosfolipid səthini yaradır.
2. İkincili hemostaz – laxtalanma faktorlarıın aktivləşməsi və trombinin əmələ gəllməsi
Laxtalanmanın başlaması:
• Zədələnmiş toxuma hüceyrələrindən, endotel hüceyrələrdən və monositlərdən (TF) toxuma faktoru sintez olunur
• Toxuma faktoru və VII a faktoru birləşərək TF-VIIa faktor kompleksini əmələ gətirir
• TF-VIIa faktor kompleksi az miqdarda trombin əmələ gətirmək üçün faktor IX və faktor X-u aktivləşdirir
• Faktor XII (və digər kontakt faktorlar) faktor XI-in aktivləşməsində az rol oynayır
Amplifikasiya
• Trombin faktor V və VIII-i uyğun olaraq faktor Va və VIIIa-ya aktivləşdirir və prosesə daha çox trombositi cəlb edir
• Trombin həmçinin faktor XI-i Xia ya aktivləşdirir
Yayılma
• TF-VIIa faktoru IX faktorunu aktivləşdirməsi nəticəsində faktor XIa sintez olunur. Əldə olunmuş IXa faktoru VIIIa faktoru ilə birlikdə tenase kompleksini əmələ gətirir ki, sonuncu da daha çox faktor X-u Xa ya çevirir
• Xa və Va faktoru kalsium və fosfolipid (PL) səthi (aktivləşdirilmiş trombositlər) ilə birlikdə protrombini (Faktor II) böyük miqdarda trombinə (Faktor IIa) çevirən protrombinaz kompleksini əmələ gətirir.
3. Fibrin laxtasının əmələ gəlməsi və sabitləşməsi
• Trombin fibrinogeni fibrin monomerlərinə çevirir və həll olunan laxta əmələ gətirir. Trombin daha sonra fibrin monomerlərini çarpaz birləşdirən və laxtanı sabitləşdirərək həll olmayan fibrin əmələ gətirən Faktor XIII-i aktivləşdirir.
4. Laxtalanmanın yavaşıması =trombin və fibrin sintezinin zəiflədilməsi
Trombin sintezinin zəifləməsi
• Laxtanın əmələ gəlməsi və formalaşması kimi, artıq yaranan trombun və laxtanın geri sorulması da çox vacib prosesdir
• Trombin membran reseptoru trombomodulinə bağlanır və Protein C-ni Aktivləşdirilmiş Protein C-yə (APC) çevirir
• APC öz kofaktoru Protein S ilə birləşərək, Va və VIIIa faktorlarını inhibə edir, laxtalanma prosesini ləngidir
• Trombomodulinə bağlı trombin qeyri-aktiv olur və artıq prokoaqulyant amilləri və ya trombositləri aktivləşdirə bilmir
• Endogen antikoaqulyant olan antitrombin trombinin fəaliyyətini, eləcə də bir sıra digər aktivləşdirilmiş amilləri, ilk növbədə Xa Faktorunu inhibə edir
Fibrinoliz
• Toxuma plazminogen aktivatoru (t-PA) plazminogeni plazminə çevirir, bu da çarpaz birləşmiş fibrini bir neçə parçalanma məhsullarına parçalayır, ən kiçiyi isə D-dimerdir
• Trombin aktivləşdirilə bilən fibrinoliz inhibitoru (TAFI) plazminin əmələ gəlməsinin qarşısını alır
• Anti-plazmin və plazminogen aktivator inhibitor-1 (PAI-1) müvafiq olaraq plazmin və t-PA-nı inhibə edir
Hemostazın 4 əsas hissədən ibarətdir:
1. İlkin hemostaz
2. İkincili hemostaz
3. Fibrin formalaşması və stabilləşməsi
4. Laxtalanma inhibitorları
1. İlkin hemostaz – vazokonstruksiya və trombosit laxtasının əmələ gəlməsi:
İlkin hemostazın əsas komponenti trombositdir. İlkin hemostaz subendotelial kollagen müşahidə olunan damar divarının zədələnməsi ilə baş verir
• Vazokonstruksiya: Qan axışını azaltmaq üçün zədə yerində vazokonstruksiya əmələ gəlir.
Yapışma: von Willebrand faktoru trombosit qlikoprotein Ib (GPIb) reseptoru vasitəsi ilə trombositləri meyudana çıxan subendotelial kollagenə yapışdırır. Digər reseptorlar da trombositlərin birbaşa kollagenə yapışmasına şərait yaradır.
Toplanma: Trombositlər GPIb reseptorlarına birləşmiş fibrinogen hesabına bir zədələnmiş damar nahiyəsində toplanır və beləliklə trombosit tıxacı əmələ gətirir. Trombositlərin toplanması həmçinin laxtalanma faktorlarının aktivləşməsini təmin edən fosfolipid səthini yaradır.
2. İkincili hemostaz – laxtalanma faktorlarıın aktivləşməsi və trombinin əmələ gəllməsi
Laxtalanmanın başlaması:
• Zədələnmiş toxuma hüceyrələrindən, endotel hüceyrələrdən və monositlərdən (TF) toxuma faktoru sintez olunur
• Toxuma faktoru və VII a faktoru birləşərək TF-VIIa faktor kompleksini əmələ gətirir
• TF-VIIa faktor kompleksi az miqdarda trombin əmələ gətirmək üçün faktor IX və faktor X-u aktivləşdirir
• Faktor XII (və digər kontakt faktorlar) faktor XI-in aktivləşməsində az rol oynayır
Amplifikasiya
• Trombin faktor V və VIII-i uyğun olaraq faktor Va və VIIIa-ya aktivləşdirir və prosesə daha çox trombositi cəlb edir
• Trombin həmçinin faktor XI-i Xia ya aktivləşdirir
Yayılma
• TF-VIIa faktoru IX faktorunu aktivləşdirməsi nəticəsində faktor XIa sintez olunur. Əldə olunmuş IXa faktoru VIIIa faktoru ilə birlikdə tenase kompleksini əmələ gətirir ki, sonuncu da daha çox faktor X-u Xa ya çevirir
• Xa və Va faktoru kalsium və fosfolipid (PL) səthi (aktivləşdirilmiş trombositlər) ilə birlikdə protrombini (Faktor II) böyük miqdarda trombinə (Faktor IIa) çevirən protrombinaz kompleksini əmələ gətirir.
3. Fibrin laxtasının əmələ gəlməsi və sabitləşməsi
• Trombin fibrinogeni fibrin monomerlərinə çevirir və həll olunan laxta əmələ gətirir. Trombin daha sonra fibrin monomerlərini çarpaz birləşdirən və laxtanı sabitləşdirərək həll olmayan fibrin əmələ gətirən Faktor XIII-i aktivləşdirir.
4. Laxtalanmanın yavaşıması =trombin və fibrin sintezinin zəiflədilməsi
Trombin sintezinin zəifləməsi
• Laxtanın əmələ gəlməsi və formalaşması kimi, artıq yaranan trombun və laxtanın geri sorulması da çox vacib prosesdir
• Trombin membran reseptoru trombomodulinə bağlanır və Protein C-ni Aktivləşdirilmiş Protein C-yə (APC) çevirir
• APC öz kofaktoru Protein S ilə birləşərək, Va və VIIIa faktorlarını inhibə edir, laxtalanma prosesini ləngidir
• Trombomodulinə bağlı trombin qeyri-aktiv olur və artıq prokoaqulyant amilləri və ya trombositləri aktivləşdirə bilmir
• Endogen antikoaqulyant olan antitrombin trombinin fəaliyyətini, eləcə də bir sıra digər aktivləşdirilmiş amilləri, ilk növbədə Xa Faktorunu inhibə edir
Fibrinoliz
• Toxuma plazminogen aktivatoru (t-PA) plazminogeni plazminə çevirir, bu da çarpaz birləşmiş fibrini bir neçə parçalanma məhsullarına parçalayır, ən kiçiyi isə D-dimerdir
• Trombin aktivləşdirilə bilən fibrinoliz inhibitoru (TAFI) plazminin əmələ gəlməsinin qarşısını alır
• Anti-plazmin və plazminogen aktivator inhibitor-1 (PAI-1) müvafiq olaraq plazmin və t-PA-nı inhibə edir
Maye mühit
Həssaslıq baxımından maye mühit az saylı bakteriyaların izolyasiyası üçün də ən uyğun mühit hesab olunur. Qida bulyonu, zənginləşdirici mühit və şəkər mühiti buna nümunədir. Bütün bu üstünlüklərinə baxmayaraq maye mühitin bəzi çatışmazlıqları da var. Məsələn, bərk mühitdən fərqli olaraq maye mühitdə qarışıq koloniyalar əmələ gəldiyi zaman və əmələ gəlmiş bakteriyaların çox zaman kolloidal suspenziya şəklində mühitdə asılı halda qalması onların təyin edilməsində çətinliklər törədir. Aşağıda bəzi maye mühit nümunələrinin tərkibi və istifadəsi göstərilmişdir.
Pepton suyu
Tərkibi: Pepton, natrium xlorid, su
İstifadəsi: Şəkər fermentasiya əsaslı rutin kultura, indol testi
Qida bulyonu
Tərkibi: Pepton suyu, ət ekstraktı
İstifadəsi: Rutin kultura
Robertson bişmiş ət bulyonu (RCM)
Tərkibi: Qida bulyonu, bişirilmiş öküz ürəyi
İstifadəsi: Anaerob bakteriya kulturası
Tetrationat bulyonu
Tərkibi: Qida bulyonu, natrium tiosulfat, kalsium karbonat, yod məhlulu
İstifadəsi: Nəcisdə salmonella kulturası
Selen-F bulyonu
Tərkibi: Pepton suyu, natrium selenid
İstifadəsi: Nəcisdə Salmonella, Şigella kulturası
Əsasi peptonlu su
Tərkibi: Pepton suyu (pH 8,6)
İstifadəsi: Vibrion mühitlərinin zənginləşdirilməsi
Qlükoza bulyonu
Tərkibi: Qida mühiti, qlükoza
İstifadəsi: Streptokoklar kimi çətin inkişaf edən orqanizmlər, qan kulturası
Beyin-ürək bulyonu
Tərkibi: Natrium sitrat, natrim xlorid, natrium fosfat, dextroza, pepton, öküz beyin və ürək bişmə suyu, natrium polianetol sulfonat (SPS)
İstifadəsi: Tam qan, sümük iliyi, bədən mayeləri kulturası
Yarım-maye mühit
Belə mühitlər bərk mühitdə aqarın qatılığını azaltmaqla (0.2-0.4 ) alınır və belə mühitlərdə bakteriyaların yayılması asan olur.
Qidalandırıcılıq faktoruna görə
• Sadə mühit
• Kompleks mühit
• Müəyyən mühit
Sadə mühit
Qidalı bulyon və pepton suyu sadə yaxud bazal mühitə yaxşı nümunələrdir.
• Qida bulyonu tərkibində pepton, ət ekstraktı, natrium xlorid və su olan sadə maye mühitdir. Üzərinə 0,5%-li qlükoza əlavə edilsə glükoza bulyonu alınır.
• Əlavə olaraq qidalı aqar rutin bakteriyaların çoxalması üçün sadə bərk mühitdir.
Kompleks mühit
Belə mühitə şokolad aqar, MacConcey aqar, Robertson bişmiş ət mühiti (RCM), Lovenşteyn-Yansen mühiti və s. aiddir. Bu mühitlər müxtəlif mürəkkəb birləşmələrdən və müxtəlif reseptlər əsasında hazırlanır. Kompleks mühitlərdə istifadə olunanlar aşağıdakılardır:
• Amin turşu mənbəyi (məsələn yumurta və maya ekstraktı)
• Su
• Karbon mənbəyi məsələn qlükoza
• Müxtəlif duzlar
Müəyyən mühit
Buna həm də sintetik mühit deyilir çünki işlədilən inqredientlər hansı məqsəd üçün istifadə olunacaqsa qabaqcadan müəyyən edilir. Onların tərkibində maya, heyvan və bitki toxumaları olmur. Belə mühitlər aşağıdakılardan hazırlanır:
• Lazımi elementlər və vitaminlər
• Bəlli mikroblar tərəfindən tələb olunan karbon və azot mənbəyi. Qlükoza yaxud qliserin karbon mənbəyi, ammonium duzları, nitratlar isə azot mənbəyi kimi istifadə olunur.
Bu mühitə misal olaraq Dubo mühitini göstərmək olar.
Həssaslıq baxımından maye mühit az saylı bakteriyaların izolyasiyası üçün də ən uyğun mühit hesab olunur. Qida bulyonu, zənginləşdirici mühit və şəkər mühiti buna nümunədir. Bütün bu üstünlüklərinə baxmayaraq maye mühitin bəzi çatışmazlıqları da var. Məsələn, bərk mühitdən fərqli olaraq maye mühitdə qarışıq koloniyalar əmələ gəldiyi zaman və əmələ gəlmiş bakteriyaların çox zaman kolloidal suspenziya şəklində mühitdə asılı halda qalması onların təyin edilməsində çətinliklər törədir. Aşağıda bəzi maye mühit nümunələrinin tərkibi və istifadəsi göstərilmişdir.
Pepton suyu
Tərkibi: Pepton, natrium xlorid, su
İstifadəsi: Şəkər fermentasiya əsaslı rutin kultura, indol testi
Qida bulyonu
Tərkibi: Pepton suyu, ət ekstraktı
İstifadəsi: Rutin kultura
Robertson bişmiş ət bulyonu (RCM)
Tərkibi: Qida bulyonu, bişirilmiş öküz ürəyi
İstifadəsi: Anaerob bakteriya kulturası
Tetrationat bulyonu
Tərkibi: Qida bulyonu, natrium tiosulfat, kalsium karbonat, yod məhlulu
İstifadəsi: Nəcisdə salmonella kulturası
Selen-F bulyonu
Tərkibi: Pepton suyu, natrium selenid
İstifadəsi: Nəcisdə Salmonella, Şigella kulturası
Əsasi peptonlu su
Tərkibi: Pepton suyu (pH 8,6)
İstifadəsi: Vibrion mühitlərinin zənginləşdirilməsi
Qlükoza bulyonu
Tərkibi: Qida mühiti, qlükoza
İstifadəsi: Streptokoklar kimi çətin inkişaf edən orqanizmlər, qan kulturası
Beyin-ürək bulyonu
Tərkibi: Natrium sitrat, natrim xlorid, natrium fosfat, dextroza, pepton, öküz beyin və ürək bişmə suyu, natrium polianetol sulfonat (SPS)
İstifadəsi: Tam qan, sümük iliyi, bədən mayeləri kulturası
Yarım-maye mühit
Belə mühitlər bərk mühitdə aqarın qatılığını azaltmaqla (0.2-0.4 ) alınır və belə mühitlərdə bakteriyaların yayılması asan olur.
Qidalandırıcılıq faktoruna görə
• Sadə mühit
• Kompleks mühit
• Müəyyən mühit
Sadə mühit
Qidalı bulyon və pepton suyu sadə yaxud bazal mühitə yaxşı nümunələrdir.
• Qida bulyonu tərkibində pepton, ət ekstraktı, natrium xlorid və su olan sadə maye mühitdir. Üzərinə 0,5%-li qlükoza əlavə edilsə glükoza bulyonu alınır.
• Əlavə olaraq qidalı aqar rutin bakteriyaların çoxalması üçün sadə bərk mühitdir.
Kompleks mühit
Belə mühitə şokolad aqar, MacConcey aqar, Robertson bişmiş ət mühiti (RCM), Lovenşteyn-Yansen mühiti və s. aiddir. Bu mühitlər müxtəlif mürəkkəb birləşmələrdən və müxtəlif reseptlər əsasında hazırlanır. Kompleks mühitlərdə istifadə olunanlar aşağıdakılardır:
• Amin turşu mənbəyi (məsələn yumurta və maya ekstraktı)
• Su
• Karbon mənbəyi məsələn qlükoza
• Müxtəlif duzlar
Müəyyən mühit
Buna həm də sintetik mühit deyilir çünki işlədilən inqredientlər hansı məqsəd üçün istifadə olunacaqsa qabaqcadan müəyyən edilir. Onların tərkibində maya, heyvan və bitki toxumaları olmur. Belə mühitlər aşağıdakılardan hazırlanır:
• Lazımi elementlər və vitaminlər
• Bəlli mikroblar tərəfindən tələb olunan karbon və azot mənbəyi. Qlükoza yaxud qliserin karbon mənbəyi, ammonium duzları, nitratlar isə azot mənbəyi kimi istifadə olunur.
Bu mühitə misal olaraq Dubo mühitini göstərmək olar.

İnfeksion xəstəliklərin tətqiqi, törədicilərin mikrobiologiya laboratoriyalarında araşdırılmasından bilavasitə asılıdır. Belə ki, törədicilər süni hazırlanmış qidalı mühitlərdə çoxaldılır və onların miqdarı, xüsusiyyətləri öyrənilərək diaqnoz qoyulur və mübarizə tədbirləri işlənib hazırlanır. Bakteriya, göbələk və viruslar bərk (aqar) yaxud maye (bulyon) süni mühitində yetişdirilir. R.Koch ilk dəfə bərk qida mühitini tətbiq etmişdir. Bu metoda görə mikroorqanizmlər, bərk qida mühiti ilə doldurulmuş kasalarda yetişdirilirdi. Mühitin hazırlanması zamanı o, jelatindən istifadə etmişdir. Jelatinin üstünlüklərinə baxmayaraq, bəzi bakteriyalar tərəfindən qida kimi istifadə edilməsi və 28 ˚C-dən yuxarı temperaturda əriməsi prosesə mənfi təsir edirdi. Koch-un asistentlərindən biri Fannie Eilshemius Hesse bərk agent olaraq jelatin əvəzinə aqardan istifadə etməyi təklif etmişdi. Jelatinlə müqayisədə, aqar bakteriyaların təsirinə az məruz qalır və 100 ˚C-də belə ərimir. Koch-un digər asistenti Richard Petri bundan sonra öz adı ilə adlandırılacaq Petri kasalarını hazırladı və onun hazırladığı kasalar bu gün də müxtəlif laboratoriyalarda geniş tətbiq edilir.
Kultura mühitinin əsas komponentləri:
• Aqar (yaxud aqar-aqar)
Bərk mühitin hazırlanmasında istifadə olunan əsas komponentlərindən biridir. Müxtəlif dəniz yosunlarından alınan bu məhsul toz halına salınmış formada yaxud uzun dilimlər şəklinə salınmış formada tətbiq olunur. Aqarın əsas tərkib hissəsi uzun zəncirli polisaxaridlərdir. Bununla yanaşı onun tərkibində müxtəlif duzlar, kalsium, magnezium, və bəzən uzun zəncirli yağ turşuları olur. Aqarların mikroorqanizmlər üçün heç bir qida dəyəri yoxdur və onların böyüməsinə heç bir təsir etmir. Aqar yüksək temperatur və yüksək əsasi və turşu mühitində hidroliz olunur, 98 ˚C-də əriyir və 42 ˚C-də bərkiyir.
• Pepton
Pepton bakteriyalar üçün əsas qida mənbəyidir və onun tərkibində müxtəlif zülal birləşmələri olur. Amin turşuların, pepsin, tripsin, fosfat, kalium və magnezium duzları, böyümə faktorları və s. peptonların əsas tərkib hissələridir. Ət bulyonu və ət ekstraktı (Lab-Lemco) da zülal mənbəyi kimi istifadə edilə bilər.
• Malt ekstraktı
Nişasta, maltoza, qlükoza, və dekstrindən hazırlanmış bu qarışıqda təxminən 5%-ə qədər zülallar, onların parçalanma məhsullar, minerallar və böyümə faktorları olur.
• Qan və serum
Əsasən kultura mühitinin zənginləşdirilməsi üçün istifadə olunur.
• Maya ekstraktı
Çoxlu miqdarda amin turşuları, böyümə faktorları və mineral duzlardan təşkil olunmuşdur.
Qidalı mühitinin növləri
Qidalı mühitlər müxtəlif xüsusiyyətlərinə görə təsnif olunur:
Mühitin fazasına görə
• Bərk mühit
• Yarım-maye mühit
• Maye mühit
Bərk mühit
Belə qidalı mühitlərdə bərklik verən agent kimi aqar istifadə olunur. Aqarın qatılığından asılı olaraq mühit bərk yaxud yarım-bərk mühit olacaqdır. Bərk mühit maye mühitlə müqayisədə az həssas olsa da bəzi mikroorqanizmlərin koloniya formasındakı spesifikliyə əsasən onların təyinatında mühüm rol oynayır. Qidalı aqar bərk mühit üçün yaxşı misaldır. Qidalı bulyon üzərinə 2%-li aqar əlavə etməklə belə aqar hazırlanır. Digər bərk mühitlərə Eosin metilen mavi aqar, şokolad aqar, MacConcey və s. aqarlar misal ola bilər. Aşağıdakı cədvəldə mikrobiologiyada istifadə olunan bəzi bərk qidalı mühitlərin tərkibi və istifadəsi göstərilmişdir:
Levnşteyn-Yansen
Tərkibi: Qaynadılmış toyuq yumurtası, mineral duz məhlulu, asparagin, yaşıl malaxit
İstifadəsi: Mycobacterum tuberculosis kulturası üçün
TCBS aqar (Thiosulfate citrate bile salt)
Tərkibi: Tiosulfat, sitrat, öd duzu, saxaroza, mavi bromotilol, mavi timol
İstifadəsi: Cholera kulturası (vibrion) üçün
Leofler serumu
Tərkibi: Qida bulyonu, glukoza, at serumu
İstifadəsi: Corinobacterum diphteriae kulturası
Deoksixolat sitrat aqar
Tərkibi: Qidalı aqar, natrium deoksixolat, laktoza və s.
İstifadəsi: Shigella spp. və Salmonella spp.
Şokolad aqar
Tərkibi: Bişirilmiş qan
İstifadəsi: Haemophilus influenza və Neisseria kulturası
Qanlı aqar
Tərkibi: Qidalı aqar, 5% qoyun yaxud insan qanı
İstifadəsi: Rutin kulturalar, Streptococcus spp. kimi çətinçoxalan orqanizmlər
Qidalı aqar
Tərkibi: Qida bulyonu, 2% aqar
İstifadəsi: Rutin kulturalar
MacConcey aqar
Tərkibi: Pepton, laktoza, natrium tauroxolat, aqar və s.
İstifadəsi: Qram neqativ bakteriyalar m əsələn Escherichia coli
Kultura mühitinin əsas komponentləri:
• Aqar (yaxud aqar-aqar)
Bərk mühitin hazırlanmasında istifadə olunan əsas komponentlərindən biridir. Müxtəlif dəniz yosunlarından alınan bu məhsul toz halına salınmış formada yaxud uzun dilimlər şəklinə salınmış formada tətbiq olunur. Aqarın əsas tərkib hissəsi uzun zəncirli polisaxaridlərdir. Bununla yanaşı onun tərkibində müxtəlif duzlar, kalsium, magnezium, və bəzən uzun zəncirli yağ turşuları olur. Aqarların mikroorqanizmlər üçün heç bir qida dəyəri yoxdur və onların böyüməsinə heç bir təsir etmir. Aqar yüksək temperatur və yüksək əsasi və turşu mühitində hidroliz olunur, 98 ˚C-də əriyir və 42 ˚C-də bərkiyir.
• Pepton
Pepton bakteriyalar üçün əsas qida mənbəyidir və onun tərkibində müxtəlif zülal birləşmələri olur. Amin turşuların, pepsin, tripsin, fosfat, kalium və magnezium duzları, böyümə faktorları və s. peptonların əsas tərkib hissələridir. Ət bulyonu və ət ekstraktı (Lab-Lemco) da zülal mənbəyi kimi istifadə edilə bilər.
• Malt ekstraktı
Nişasta, maltoza, qlükoza, və dekstrindən hazırlanmış bu qarışıqda təxminən 5%-ə qədər zülallar, onların parçalanma məhsullar, minerallar və böyümə faktorları olur.
• Qan və serum
Əsasən kultura mühitinin zənginləşdirilməsi üçün istifadə olunur.
• Maya ekstraktı
Çoxlu miqdarda amin turşuları, böyümə faktorları və mineral duzlardan təşkil olunmuşdur.
Qidalı mühitinin növləri
Qidalı mühitlər müxtəlif xüsusiyyətlərinə görə təsnif olunur:
Mühitin fazasına görə
• Bərk mühit
• Yarım-maye mühit
• Maye mühit
Bərk mühit
Belə qidalı mühitlərdə bərklik verən agent kimi aqar istifadə olunur. Aqarın qatılığından asılı olaraq mühit bərk yaxud yarım-bərk mühit olacaqdır. Bərk mühit maye mühitlə müqayisədə az həssas olsa da bəzi mikroorqanizmlərin koloniya formasındakı spesifikliyə əsasən onların təyinatında mühüm rol oynayır. Qidalı aqar bərk mühit üçün yaxşı misaldır. Qidalı bulyon üzərinə 2%-li aqar əlavə etməklə belə aqar hazırlanır. Digər bərk mühitlərə Eosin metilen mavi aqar, şokolad aqar, MacConcey və s. aqarlar misal ola bilər. Aşağıdakı cədvəldə mikrobiologiyada istifadə olunan bəzi bərk qidalı mühitlərin tərkibi və istifadəsi göstərilmişdir:
Levnşteyn-Yansen
Tərkibi: Qaynadılmış toyuq yumurtası, mineral duz məhlulu, asparagin, yaşıl malaxit
İstifadəsi: Mycobacterum tuberculosis kulturası üçün
TCBS aqar (Thiosulfate citrate bile salt)
Tərkibi: Tiosulfat, sitrat, öd duzu, saxaroza, mavi bromotilol, mavi timol
İstifadəsi: Cholera kulturası (vibrion) üçün
Leofler serumu
Tərkibi: Qida bulyonu, glukoza, at serumu
İstifadəsi: Corinobacterum diphteriae kulturası
Deoksixolat sitrat aqar
Tərkibi: Qidalı aqar, natrium deoksixolat, laktoza və s.
İstifadəsi: Shigella spp. və Salmonella spp.
Şokolad aqar
Tərkibi: Bişirilmiş qan
İstifadəsi: Haemophilus influenza və Neisseria kulturası
Qanlı aqar
Tərkibi: Qidalı aqar, 5% qoyun yaxud insan qanı
İstifadəsi: Rutin kulturalar, Streptococcus spp. kimi çətinçoxalan orqanizmlər
Qidalı aqar
Tərkibi: Qida bulyonu, 2% aqar
İstifadəsi: Rutin kulturalar
MacConcey aqar
Tərkibi: Pepton, laktoza, natrium tauroxolat, aqar və s.
İstifadəsi: Qram neqativ bakteriyalar m əsələn Escherichia coli

II BEYNƏLXALQ LABORATORİYA TƏBABƏTİ KONFRANSI
"Unolab" MMC II Beynəlxalq Laboratoriya Təbabəti Konfransında iştirak edir.
Konfransda sponsor kimi iştirak edən "Unolab" MMC-nin stendinə yaxınlaşan həkimlər, laborantlar və digər konfrans iştirakçılarına şirkətin təqdim etdiyi məhsullar və göstərdiyi xidmətlər barədə ətraflı məlumat verilmişdir.
Konfransda sponsor kimi iştirak edən "Unolab" MMC-nin stendinə yaxınlaşan həkimlər, laborantlar və digər konfrans iştirakçılarına şirkətin təqdim etdiyi məhsullar və göstərdiyi xidmətlər barədə ətraflı məlumat verilmişdir.

17-İYUN - TİBB İŞÇİLƏRİNİN PEŞƏ BAYRAMI 2022 İL
Unolab MMC, 17 İyun-Tibb İşçilərinin Peşə Bayramı münasibəti ilə bütün tibb işçilərini təbrik edir, işlərində uğurlar arzulayır







